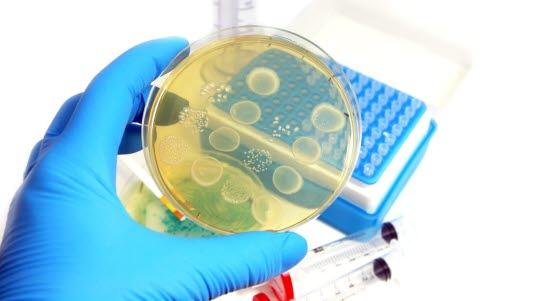
Dyrkningsmedium

Non-tuberkuløse mykobakterier (NTM)
Non-tuberkuløse mykobakterier er en gruppe bakterier som er beslektet med tuberkulosebakterien. De er sjelden årsak til sykdom blant ellers friske mennesker, men kan gi infeksjon ved svekket immunitet.
Sist oppdatert:
9. feb. 2021
Hva er non-tuberkuløse mykobakterier?
Non-tuberkuløse mykobakterier (NTM) er en gruppe bakterier som er beslektet med den bakterien som er årsaken til tuberkulose, Mycobacterium tuberculosis. Tidligere kalte man NTM for atypiske mykobakterier.
Bakteriene ligner tuberkulosebakterien i utseende i mikroskop, og de oppfører seg også svært likt. Men NTM er fredeligere, og kan være tilstede på kroppen uten å gi sykdom. Dersom de fører til sykdom, er denne som regel mildere enn tuberkulose-sykdommen. NTM kan imidlertid forårsake sykdom hos personer med svekket immunforsvar, og er en hyppig sykdom blant pasienter med hiv-aids. Bakteriene kan også føre til sykdom hos ellers friske barn fordi barns immunsysten er mer umodent enn det voksne.
Forekomst
Sykdommen har ikke vært meldepliktig til folkehelseinstituttet etter 2009. Tall for forekomst er derfor usikre. Det analyseres nå ca. 300 prøver som inneholder NTM ved folkehelseinstituttet hvert år.
Vanligvis opptrer kun enkelt-tilfeller, det vil si at det er sjelden med utbrudd blant flere personer. Smitten kan overføres med vann eller vanndamp - for eksempel fra basseng. Man kan også smittes via mage-tarmkanalen ved forurenset jord eller vann. Sykdommene smitter ikke mellom mennesker.
Symptomer
Bakteriene medfører først og fremst sykdom hos personer som av forskjellige årsaker har svekket immunapparat. Hos små barn er den vanligste sykdommen en betennelse i en lymfekjertel på halsen, mens barnet ellers kan være upåvirket og friskt. Diagnosen blir ikke stilt med sikkerhet før kjertelen blir fjernet kirurgisk og undersøkt med tanke på bakterier. Mykobakteriene kan også føre til infeksjoner i lungene hos både barn og voksne, og spesielt utsatt er personer med annen kronisk lungesykdom som for eksempel cystisk fibrose. Hos pasienter med hiv-aids kan sykdommen medføre infeksjoner i alle deler av kroppen.
Dersom de atypiske bakteriene fører til sykdom i lungene, kan dette være vanskelig å skille fra ekte tuberkulose både ved legeundersøkelse og ved røntgen av lungene. Diagnosen stilles først når en har fått undersøkt oppspytt eller vevsprøver - enten ved mikroskopi eller dyrkning. Både tuberkulose- og atypiske mykobakterier vokser svært langsomt. Det er derfor normalt at det kan ta mange uker før endelig svar er klart.
Behandling
Dersom en påviser atypiske mykobakterier hos personer som er uten sykdomsplager i øyeblikket, er det vanlig å avvente uten behandling. De aller fleste vil bli bra av seg selv. Dersom bakteriene fører til sykdom, er behandling nødvendig. Sykdom i en lymfekjertel på halsen fjernes kirurgisk, og behøver vanligvis ingen medisiner. Lungeinfeksjoner, og mer utbredte infeksjoner hos pasienter med svekket immunapparat, krever langvarig behandling med antibiotika (tuberkulostatika), samme typer medisiner som benyttes ved behandling for tuberkulose.
BCG-vaksinen som brukes forebyggende mot tuberkulose har liten eller ingen effekt mot atypiske mykobakterier. Som ledd i forebyggingen er det viktig at bassengbad er tilstrekkelig klorbehandlet.
Barn med påvist NTM kan gå i barnehage dersom han/hun er feberfri og i god allmenntilstand.
Prognose
Utsiktene til helbredelse er svært gode for pasienter som ellers er friske. Hos pasienter med svekket immunsystem og/eller svekket lungefunksjon, kan denne typen infeksjoner være alvorlige og kreve intens og langvarig behandling.
Dette dokumentet er basert på det profesjonelle dokumentet Non-tuberkuløse mykobakterier . Referanselisten for dette dokumentet vises nedenfor
- Folkehelseinstituttet. Mykobakterieinfeksjoner (non-tuberkuløse mykobakterier, NTM) - veileder for helsepersonell. Sist oppdatert 17.02.2019. Siden lest 05.02.2021 www.fhi.no
- Griffith DE, Aksamit T, Brown-Elliott BA, et al. An official ATS/IDSA statement: diagnosis, treatment, and prevention of nontuberculous mycobacterial diseases. Am J Respir Crit Care Med 2007; 175:367. PubMed
- Blystad H. Atypisk mykobakterieinfeksjoner (mykobakterieinfeksjoner med NTM). Smittevernhåndboka. Folkehelseinstituttet. Sist oppdatert 09.04.2015.
- Steenberg CK, Bredberg A, Eiken R. Mann i 70-årene med tungpust og ataksi etter BCG-instillasjon mot blærekreft. Tidsskr Nor Legeforen 2021. doi:10.4045/tidsskr.20.0371 DOI